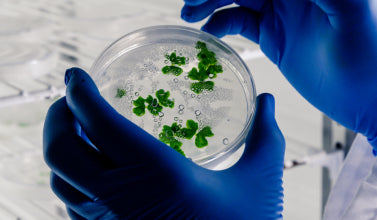

Frequently Asked Questions
What makes Earthbaby unique compared to other baby care brands?
It’s the why, what, and how behind Earthbaby.
- WHY: We believe natural is safest for little ones.
- HOW: We balance traditional ingredients with skincare science. Every product is made in FDA-approved facilities, lab and derma-tested for safety.
- WHAT: Radical transparency. We proudly display the % natural origin on every product — something only a handful of brands globally do.
Can I use Earthbaby products?
Of course! If it’s safe for babies, it’s safe for us. Many parents love using our soaps, oils, and powders themselves. For example, our Ubtan Sunni Pindi doubles up as a gentle face wash for moms, or even as a DIY spa ritual.
Do Earthbaby products help with common baby skin concerns?
Yes. From dryness to rashes, our “Shop by Concern” menu makes it easy to find the right product. Still unsure? Just message us — we’re happy to help.
What certifications do Earthbaby products have?
Yes, proof matters. That’s why our products carry trusted certifications:
-
MADE SAFE Australia → toxin-free formulations
-
Allergy Certified → allergens clearly labeled (e.g. nuts, soy)
-
PETA Cruelty-Free → never tested on animals
-
Vegan → most products (except Kumkumadi, Lipsticks, Milk & Sandal Soap, Ahimsa Honey)
- Dermatologically tested → for all formulated products
Do you test your products on animals?
Never. All Earthbaby products are cruelty-free. We test on ourselves first (founders, team, family, friends). And except for a few traditional formulations with milk or honey, we are proudly vegan.
Where can I buy Earthbaby products?
Online: Right here on earthbaby.in, plus Amazon and FirstCry. Mumzworld and Noon in UAE.
Offline: Go Native stores in Bangalore, and The Healthy Mother Sanctum in Hyderabad.